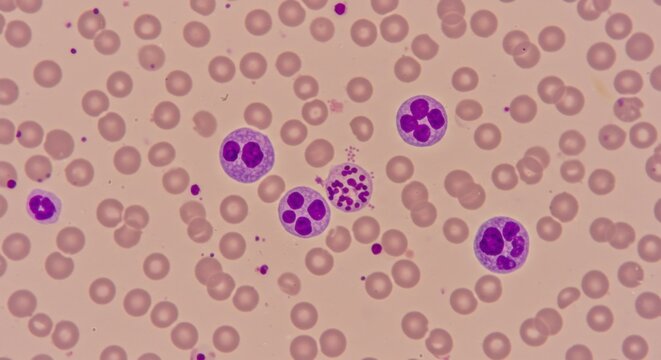
Microscopic blood smear displaying human neutrophils against red blood cells background

- Home >
- Stock Photos >
- Colorful Microscopic View of Red and Pink Cells
Colorful Microscopic View of Red and Pink Cells Image

Detailed depiction of red and pink biological cells set against a black backdrop is present. This image can be used for educational materials, scientific presentations, medical research publications, or as visually appealing content in marketing for related fields. Ideal for illustrating cellular biology concepts and showing vibrant cellular imagery for science-focused audiences.
Credit Photo
If you would like to credit the Photo, here are some ways you can do so
Text Link
photo Link
<span class="text-link">
<span>
<a target="_blank" href=https://pikwizard.com/photo/colorful-microscopic-view-of-red-and-pink-cells/7375db6f06576b01ccbd3ae686408fc3/>PikWizard</a>
</span>
</span>
<span class="image-link">
<span
style="margin: 0 0 20px 0; display: inline-block; vertical-align: middle; width: 100%;"
>
<a
target="_blank"
href="https://pikwizard.com/photo/colorful-microscopic-view-of-red-and-pink-cells/7375db6f06576b01ccbd3ae686408fc3/"
style="text-decoration: none; font-size: 10px; margin: 0;"
>
<img src="https://pikwizard.com/pw/medium/7375db6f06576b01ccbd3ae686408fc3.jpg" style="margin: 0; width: 100%;" alt="" />
<p style="font-size: 12px; margin: 0;">PikWizard</p>
</a>
</span>
</span>
Free (free of charge)
Free for personal and commercial use.
Author: People Creations